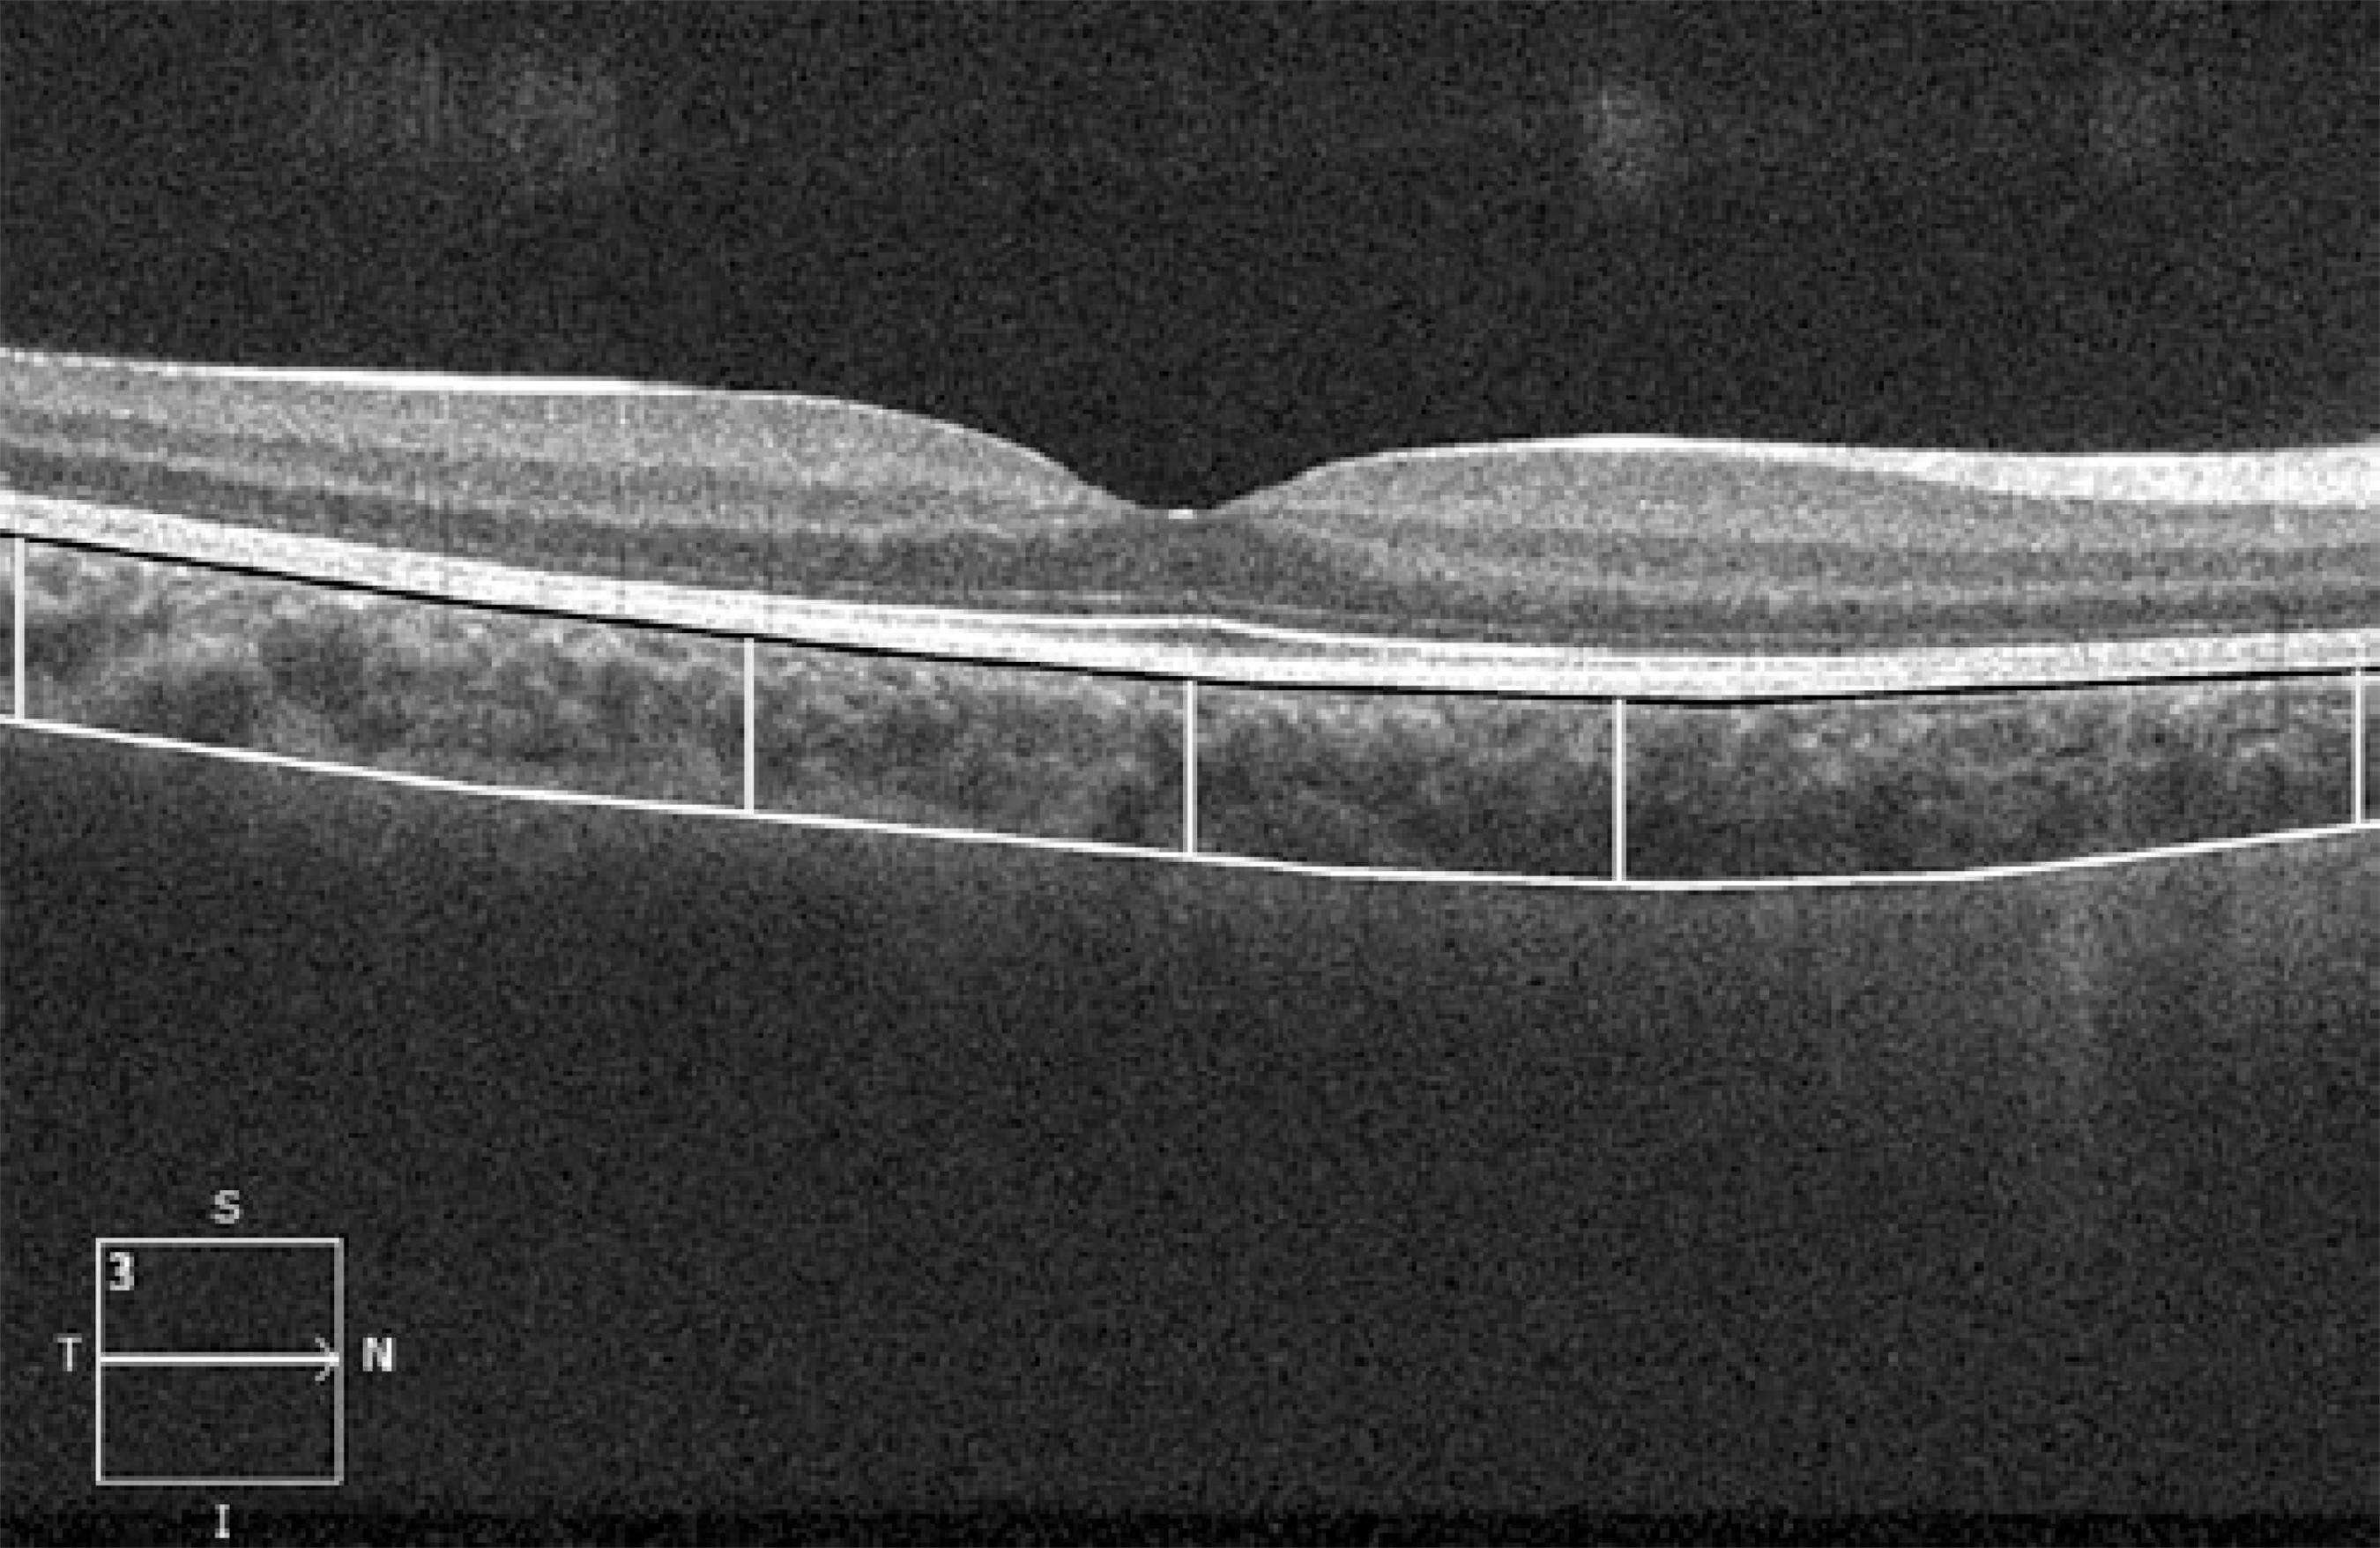

INTRODUCTION
Thinning and loss of the choroidal vasculature may lead to photoreceptor damage-related diseases( 1 ), including central serous chorio-retinopathy (CSC)( 2 ), age-related macular degeneration (AMD)( 3 ), choroidal melanoma( 4 ), Vogt-Koyanagi-Harada (VKH) syndrome( 5 ), and others( 6 ).
Choroidal thickness (CT) can be measured using different techniques such as ultrasonography and histology. However, the location of the choroid behind the pigmented cells of the retina attenuates incident light and reduces the reliability of these methods. In recent years, spectral-domain optical coherence tomography (SD-OCT) has been used to assess choroidal tissue in vivo and in real time with an acceptable reproducibility and sensitivity( 7 - 10 ). Previous studies in a healthy adult population report a range of central CT from 270 to 350 μm( 11 ). The eyes of healthy children differ from those of adults, and the influence of a normal developmental process on the choroidal structure can be evaluated by determining CT in children of various ages. There are limited studies evaluating CT in healthy children using SD-OCT. In these studies, CT measurements were performed using the Heidelberg Spectralis (Heidelberg Engineering, Heidelberg, Germany) OCT device, and the correlation with age and other factors such as axial length (AL) and refractive error was reported to be contrary( 12 - 15 ).
In this study, we aimed to determine CT in a healthy pediatric population aged between 4 and 18 years using Cirrus HD-OCT (Carl Zeiss Meditec Inc., Dublin, CA, USA). To the best of our knowledge, this is the first study using Cirrus HD-OCT to measure CT in a pediatric population.
METHODS
This prospective study was approved by the institutional medical ethics committee and conducted in accordance with the Declaration of Helsinki for research in human subjects. Written informed consent was obtained from the parents of the children after explaining the imaging modality to them and to the child.
In this study, we evaluated 137 healthy Turkish children who visited our clinic for refractive error examinations between March 2013 and September 2013. Children aged between 4 and 18 years of age with no known current or previous ocular disease or ocular medication were included. We divided the subjects into 3 groups on the basis of age: 4-6 years, 7-12 years, and 13-18 years. Children aged younger than 4 years were excluded because they were considered unable to cooperate with OCT. We also excluded all patients with maculopathy, myopia of more than 2 diopters (D), congenital glaucoma, past history of prematurity, previous eye trauma or eye surgery, and previous ocular abnormalities such as strabismus, amblyopia, congenital cataract, and vitreo-retinal disorders. We also excluded children who could not cooperate with OCT examination.
Before OCT, each child underwent a complete ophthalmic examination, including best-corrected visual acuity (BCVA) as the logarithm of the minimum angle of resolution (logMAR), cycloplegic refraction, evaluation of ocular alignment, slit lamp biomicroscopy, and fundus examination. Cycloplegic refraction was performed with an autorefractometer (Topcon KR 8800), after applying 3 drops, 5 minutes apart, of cyclopentolate 0.5%. Spherical equivalent (SE) refraction was calculated as the sum of the value of the spherical value and half of the cylindrical value. AL was determined using a Nidek AL-Scan optical biometer (Nidek Co, Ltd.) before cycloplegia. All examinations were performed between 13:00 to 15:00 to avoid diurnal variations. However, these can be different for each individual.
Optical coherence tomography imaging
The SD Cirrus high definition (HD)-OCT light source is centered on a wavelength of 800 nm, achieving 5 µm axial resolutions in tissue. Previously, the full thickness of the choroid could not be seen in most eyes because of scattering and insufficient light penetration beyond the retinal pigment epithelium (RPE), as well as signal strength roll-off distal to the zero-delay line. Selective pixel profiling available in the newest software (Version 6) generates a HD 5-line raster image from 20 B-scans taken at a single location. This processing software is comparable to frame averaging, but is unique in that images are generated by evaluating all of the pixel data to reduce noise and to construct the best possible image. Decreased signal strength posterior to the RPE is compensated by this image enhancement software, which enables visualization of the border where choroidal tissue meets sclera and allows CT measurements to be performed.
The images were taken in the usual manner and were not inverted to bring the choroid into closer proximity of the zero-delay line, because image inversion using the Cirrus software results in a low-resolution, pixelated image. The protocol of HD 5 Line Raster spaced at 0.25 mm was performed centering on the fovea and consisted of 6-mm parallel lines with 1024 A-scans/B-scans and averaging 4 B-scans per image. In this study, images had to be at least 6 out of 10 in intensity and taken as close to the fovea as possible, imaging the thinnest point of the macula with the understanding that slight differences in positioning could affect the measured thicknesses. The right eye of each subject was selected for analysis.
The choroid was visualized by Cirrus HD-OCT with the enhanced depth imaging system (EDI) according to a previously described method. ( 16 )The choroid was imaged by positioning an OCT camera close enough to the eye to obtain an inverted image. Using the Cirrus linear measurement tool, 1 experienced examiner measured CT thickness perpendicularly from the outer edge of the hyper-reflective RPE to the inner sclera at 1000 µm intervals temporal and nasal to the fovea, up to 3000 µm (temporal and nasal CT, respectively; Figure 1). The same examiner performed 2 additional measurements and the average of the 3 measurements was used for the statistical analyses.
Figure 1 A representative Cirrus HD-OCT image. The lines show choroidal thickness measurements retrieved perpendicularly from the outer edge of the hyper-reflective retinal pigment epithelium (black line) to the border with the sclera (white line). Choroidal thickness was measured at 5 points, the subfoveal area, and points 1 and 3 mm temporal and nasal to the fovea (yellow lines).
Statistical analyses
Statistical analysis was performed using SPSS 21.0 for Windows (SPSS Inc., Chicago, IL, USA). The data were normally distributed on the Kolmogorov-Smirnov test (p>0.05). A paired t-test and 1-way ANOVA was used to analyze the differences in CT between the age groups. Pearson’s correlation coefficients were used to evaluate the effect of SE, AL, central foveal thickness (CFT), age, and sex on the CT. A p value of <0.05 was considered to be statistically significant.
RESULTS
In total, 137 children (57 boys, 80 girls) were included in this study. The mean age of the children was 10.0 ± 4.7 years (range, 4-18 years). The mean SE was -0.24 ± 1.24 D (range, -2.00 D to +2.25 D). The AL was 23.3 ± 1.2 mm (range, 20-25.5 mm). Table 1 shows the characteristics of the children and the right eye for each age group.
Table 1 Characteristics of the children and the right eye by age group
| Age group | No subjects | Percent (%) | Mean SE (SD) Diopters | Range diopters | Mean AL (SD)mm | Range mm |
|---|---|---|---|---|---|---|
| 4-18 years | 137 | 100.0 | -0.24 (1.24) | -2.00 to +2.25 | 23.1 (1.2) | 20-27 |
| 4-6 years | 48 | 35.0 | 0.64 (0.43) | -0.50 to +1.25 | 22.5 (0.8) | 21-24 |
| 7-12 years | 39 | 28.4 | -0.33 (1.10) | -2.00 to +1.25 | 23.1 (1.0) | 21-26 |
| 13-18 years | 50 | 36.4 | -0.97 (1.30) | -2.00 to +1.25 | 23.8 (1.1) | 22-27 |
No= number; SE= spherical equivalent; AL= axial length; SD= standard deviation.
The mean central CT was 388.2 ± 50.0 µm (range, 241-464 µm). The CT at 1 and 3 mm nasal to the fovea was 334.1 ± 49.7 µm (range, 244-433 µm) and 306.1 ± 44.9 µm (range, 220-421 µm), respectively. The CT at 1 and 3 mm temporal to the fovea was 347.6 ± 49.4 µm (range, 249-469 µm) and 365.1 ± 44.9 µm (range, 273-457 µm), respectively. The CT at 1 and 3 mm nasal and temporal to the fovea was significantly thinner than the central CT (p<0.001). The CT at 1 and 3 mm temporal to the fovea was significantly thicker than the CT at 1 and 3 mm nasal to the fovea (p<0.001). Table 2 shows the mean central CT and the mean for 1 mm and 3 mm nasal and temporal quadrants by age.
Table 2 Distribution of choroidal thickness values using Cirrus HD-OCT
| Mean CCT (SD) | Mean CTN1 (SD) | Mean CTT1 (SD) | Mean CTN3 (SD) | Mean CTT3 (SD) | |
|---|---|---|---|---|---|
| 4-18 years | 388.2 (50.01) | 334.1 (49.7) | 347.6 (49.4) | 306.1 (44.9) | 365.1 (44.9) |
| 4-6 years | 382.4 (41.10) | 328.6 (51.0) | 346.3 (47.3) | 312.8 (51.1) | 356.7 (46.4) |
| 7-12 years | 390.6 (49.40) | 323.5 (41.4) | 347.3 (45.4) | 304.6 (42.5) | 377.9 (39.6) |
| 13-18 years | 392.0 (58.00) | 347.7 (52.1) | 349.0 (54.9) | 300.8 (40.3) | 363.1 (45.9) |
The thickness measurements are expressed in μm; th= percentil, SD= standard deviation; CTN1= nasal choroidal thickness 1 μm; CTN3= nasal choroidal thickness 3 μm; CTT1= temporal choroidal thickness 1 μm; CTT3= temporal choroidal thickness 3 μm.
There was no statistically significant difference in central CT among subgroups. There was also no significant difference in 1 mm temporal and 3 mm nasal and temporal CT among the age groups. The only significant difference was found for 1 mm nasal CT, which was thicker in the group aged 13-18 years than group aged 7-12 years (p=0.02; Figures 2 and 3).
The difference in central CT between males and females was not statistically significant after adjustment for age and AL (p=0.49). There was no significant correlation between central CT and age, SE, or AL (p=0.18, p=0.41, p=0.31, respectively). Correlation analysis showed that the 3 mm nasal CT was thicker in males than in females (r=0.15, p=0.03) and the 3 mm nasal CT was positively correlated with SE (r=0.23, p=0.003; Table 3).
Table 3 Pearson's correlation of choroidal thickness quadrants
| CCT | CTN1 | CTN3 | CTT1 | CTT3 | ||||||||||
|---|---|---|---|---|---|---|---|---|---|---|---|---|---|---|
| r | P | r | P | r | P | r | P | r | P | |||||
| Age | 0.079 | 0.181 | 0.129 | 0.066 | -0.126 | 0.072 | -0.030 | 0.362 | 0.029 | 0.369 | ||||
| Gender | -0.111 | 0.099 | -0.081 | 0.174 | 0.158 | 0.033 | -0.019 | 0.411 | 0.014 | 0.436 | ||||
| SE | -0.056 | 0.259 | 0.060 | 0.244 | 0.238 | 0.003 | 0.141 | 0.050 | 0.099 | 0.125 | ||||
| AL | -0.001 | 0.494 | -0.006 | 0.471 | -0.119 | 0.083 | -0.044 | 0.305 | -0.025 | 0.384 | ||||
CCT= central choroidal thickness; CTN1= Nasal choroidal thickness 1 μm; CTN3= nasal choroidal thickness 3 μm; CTT1= temporal choroidal thickness 1 μm; CTT3= temporal choroidal thickness 3 μm.
The mean CFT was 242.1 ± 21.3 µm (range 188-297 µm). Central CT was not correlated with mean CFT on Pearson’s correlation analysis (r=0.001, p=0.49).
DISCUSSION
Few studies have evaluated CT in the pediatric population and the factors that influence CT remain unclear. In this study we aimed to evaluate the mean values and determinants of CT among healthy children.
The previous studies evaluating CT in childhood were performed with SD-OCT devices, which use EDI technology. EDI-OCT measures the distance between the RPE and the chorio-scleral interface to obtain the CT. We evaluated the choroid features using another commercially available EDI-OCT system, Cirrus HD OCT (Carl Zeiss Meditec Inc.).
In the present study, the central CT was higher (mean, 388.2 ± 50.0 µm) compared with previous studies of CT in children( 12 - 15 , 17 ). This result may be the result of differences in the measuring software, OCT light source, ethnicity, or characteristics such as age, SE, or AL. The mean value of central CT in children in the present study was also higher than that determined in healthy adults in previous studies( 18 - 22 ).
The relationship between age and CT is controversial. Some reports have suggested that CT decreases progressively with age( 18 - 21 , 23 , 24 ). Margolis( 18 ) reported a 1.5 µm thinning in CT for each year of life. Park and Oh( 13 ) found a significant negative correlation between central CT and age among 48 healthy Korean children aged between 4 and 10 years. The thinning of CT with age in those previous studies was related to degenerative vascular changes( 18 , 19 )and stretching of tissue secondary to eyeball elongation( 13 ).
Conversely, Bidaut-Garnier et al.( 12 ) reported that central CT showed a significant positive relationship with age in 348 eyes from 174 children. Similarly, Read et al.( 14 ) determined a significantly thinner CT value in early childhood (4-6 years) compared with older children. These findings may reflect the natural growth of the eye during childhood. However, some studies did not find a correlation between CT and age. Agawa et al.( 25 ) and Li et al.( 22 ) did not identify any correlation between CT and age in eyes with AL <25 mm. Ruiz-Moreno et al.( 17 )compared a group of healthy children aged 3-17 years with a group of healthy adults aged 25-85 years. They found that no significant difference in central CT between the pediatric population and the adults.
In the present study, there was no correlation between central CT and age in healthy children, which was compatible with findings of Agawa et al.( 25 ). However, we did observe that the average CT 1 mm nasal to the fovea was significantly thicker in children aged 13-18 years than in those aged 7-12 years.
Many of the previous studies reported a negative correlation between central CT and AL or SE( 12 , 14 , 26 - 28 ). However, Park and Oh( 13 ) did not find any correlation between those parameters. In the present study, central CT was not correlated with AL or SE, which agrees with the findings of Park and Oh( 13 ).
Li et al.( 22 ) found a thicker subfoveal choroid in men compared with women among 93 healthy Danish university students with the same AL. Their finding of sex-associated differences in CT could be the result of differences in hormonal exposure. Recently, the same authors reported that CT in girls increased with body height and sexual maturation, whereas it did not change in boys. The results suggest that puberty promotes choroidal thickening in girls, an effect that may be mediated by the pubertal growth spurt. The lack of a pubertal effect in boys may be related to a smaller proportion of boys in that study having entered puberty( 29 ). However, CT was not correlated with gender in the present study, which is consistent with the findings of Bidaut-Garnier et al.( 12 )and Park and Oh( 13 ). Therefore, we suggest that the effect of hormones does not have a significant influence on CT in children, although we acknowledge that the hormonal hypothesis is partially valid. Further studies of pediatric populations are needed to better understand the effect of hormones.
According to our findings, in children the central CT was highest, followed by the temporal and the nasal CT, similar to reports on healthy adults( 9 , 18 , 20 , 21 , 24 ). However, some previous studies of pediatric populations reported that CT was the highest in the temporal choroid( 13 , 17 ). The differences in CT between adults and children may be a consequence of choroidal vascular remodeling and maturation. The fovea has higher metabolic needs than the surrounding retina, and this may lead to a decrease in the temporal CT, while the subfoveal choroid is spared.
To the best of our knowledge, this is the first study of CT measurements among Turkish children using Cirrus HD-OCT. The choroid was the thickest in the subfoveal area in this study population, followed by the temporal and nasal sectors at 1 mm and 3 mm from the fovea. In addition, AL, SE, age, and gender did not significantly affect the CT. We believe that these findings may provide useful background data to diagnose and monitor retino-choroidal diseases in children. However, a variety of factors, for example, the topographic features of the retina, the impression of other ocular anatomic tissues, and differences in the optics of the eye may lead to focal changes in CT. Therefore, larger, long-term prospective studies are needed to reveal age-related changes in CT and the influencing factors.